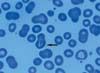
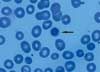
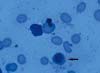

- Clinical Technology
- Adult Immunization
- Hepatology
- Pediatric Immunization
- Screening
- Psychiatry
- Allergy
- Women's Health
- Cardiology
- Pediatrics
- Dermatology
- Endocrinology
- Pain Management
- Gastroenterology
- Infectious Disease
- Obesity Medicine
- Rheumatology
- Nephrology
- Neurology
- Pulmonology
What Is the Cause of Macrocytosis and Dyspnea in an Older Man?
A 78-year-old man presented to theemergency department with a 3-weekhistory of progressive shortness of breathand cough with blood-streaked, yellowishsputum. The patient had dyspnea onexertion limited to 2 blocks, 2-pilloworthopnea, paroxysmal nocturnal dyspnea,and nocturia. Neither fever norchills were present. He had lost 7.2 kg(16 lb) during the last year.
Figure 1
Figure 2
A 78-year-old man presented to theemergency department with a 3-weekhistory of progressive shortness of breathand cough with blood-streaked, yellowishsputum. The patient had dyspnea onexertion limited to 2 blocks, 2-pilloworthopnea, paroxysmal nocturnal dyspnea,and nocturia. Neither fever norchills were present. He had lost 7.2 kg(16 lb) during the last year.
The medical history includedchronic obstructive pulmonary disease,hypertension, and type 2 diabetesmellitus; medications were metformin,aspirin, metoprolol, and lisinopril.The patient smoked 2 cigars a dayand denied excessive alcohol consumption.His brother died at age 39 of amyocardial infarction; 2 cousins hadthalassemia.
Respiratory distress, pale skin, andincreased jugular venous pressure (jugularvenous column was 11 cm above thesternal angle) were noted. Lung examinationrevealed bilateral crackles halfwayup, with decreased breath sounds anddullness to percussion. An S3 with a nonradiating,soft systolic murmur at the leftsternal border was heard. The spleenwas enlarged. The knees had bilateral 2+pitting edema.
White blood cell count was2500/?L; hemoglobin, 5 g/dL; hematocrit,15.8%; platelet count, 128,000/?L; and mean corpuscular volume,127 ?m3. Liver function tests and coagulationprofile results were normal.Vitamin B12, folic acid, methylmalonicacid, and homocysteine levels were normal.The peripheral smear (Figures 1and 2) demonstrated increased monocyteswith bizarre, stippled, megaloblasticred blood cells and large platelets.
A chest film revealed cardiomegalywith pulmonary edema. The echocardiogramshowed normal left ventricular functionwith mild tricuspid regurgitation.
High-output congestive heartfailure was diagnosed. The patientwas admitted to the hospital; nitrates,morphine, angiotensin-convertingenzyme inhibitors, and furosemidewere given for the heart failure, andpacked red blood cells were administeredto increase the hemoglobinconcentration.

Figure 3
Figure 4
Because of the patient's anemiaand splenomegaly, a hematologist wasconsulted. A bone marrow aspirate(Figures 3 - 5) revealed dyserythropoiet-ic cells, increased marrow monocytes, aleftward shift, and ringed sideroblasts.The total blasts and promyelocytes were11.5%; refractory anemia with excessblasts was identified. Six red blood celltransfusions stabilized the patient's condition;he was discharged from thehospital.
Early referral to a hematologist iswarranted for patients with macrocytosisfor which there is no obvious cause. Thispatient was referred to a hematologist. Herefused all but symptomatic treatment.
The myelodysplastic syndromes(Table)-clonal hematologic disorderscharacterized by ineffective hematopoiesis-need to be consideredin the differential diagnosis of patientswith a macrocytic anemia, particularlythose who are older than 50years. These preleukemic conditionsmanifest as slowly developing anemiathat is refractory to standardtherapy and may develop into acutemyelogenous leukemia (AML).Median age at onset is the seventhdecade of life; approximately 60%of patients are men.1
21% - 30% blasts; normal
or hypercellular marrow

Figure 5
Since a subacute form of AMLwas first recognized in 1949,2-4 manyterms-including refractory anemia,preleukemia, oligoblastic leukemia,smoldering acute leukemia, refractorydysmyelopoietic dysplasia, andhematopoietic dysplasia-have beenused to describe the syndromes ofproliferative hematopoietic failurethat often progress to AML.5-7
PATHOGENESIS
Most primitive progenitorsgive rise to red cells, platelets, neutrophils,eosinophils, and basophils.8,9 Neoplastic transformation occurs atvarious levels of development. In myelodysplasia,malignant transformationat the level of a myeloid stem cellcan result in chromosomal abnormalities.Patients with balanced chromosomaltranslocation are more likely tohave overt leukemia; those with unbalancedtranslocation (eg, trisomiesor partial chromosomal deletions) areprone to ineffective hematopoiesis,which leads to increased marrow cellularity.Inadequate cell maturation resultsin peripheral cytopenias.10,11
Apoptosis, or programmed celldeath, increases in patients whohave myelodysplasia, with futile cycling of blood cell precursors andimpaired production of mature bloodcells.12,13 The sensitivity of red cellprecursors to erythropoietin is decreased,as is the myeloperoxidaseand microbicidal activity of neutrophils.Platelets are functionallydefective.
DIFFERENTIAL DIAGNOSIS
Hereditary dysplasias, such ashereditary sideroblastic anemia,Fanconi anemia, Diamond-Blackfansyndrome, Kostmann syndrome,and Schwachman syndrome, needto be included in the differential.Also consider vitamin B12/folatedeficiency; toxicity from drugs, alcohol,and chemotherapeutic agents;radiation or benzene exposure;renal failure; tuberculosis; autoimmunedisease; viral infections,including those caused by the Epstein-Barr virus, parvovirus, andHIV; and paroxysmal nocturnalhemoglobinuria.
DIAGNOSIS
Patients with myelodysplasiamay present with 1 or more of thefollowing:
- Bleeding.
- Bruising.
- Dyspnea on exertion.
- Infection.
- Leukopenia.
- Progressive fatigue.
- Splenomegaly.
- Thrombocytopenia.
Confirmation of the diagnosisprimarily relies on morphologic findings.Examine the bone marrow todetect cytogenetic abnormalities.Fluorescence in situ hybridization isan important tool for identifying clonalgenetic abnormalities.
Anemia, neutropenia, and/orthrombocytopenia are common findings.Bone marrow has normal orincreased cellularity; megaloblasticred cell precursors with multiple nucleior asynchronous maturation ofthe nucleus and cytoplasm may benoted. Ringed sideroblasts-erythroidprecursors with iron-ladenmitochondria-are seen occasionally.Mature neutrophils may be hypogranularand hypolobulated (pseudo-Pelger-Huët anomaly).
Megakaryocytes have fewnuclear lobes and are small (micromegakaryocytes).Dysplastic abnormalitiesin all lines can include nuclear and cytoplasmic blebs, karyorrhexis,and misshapen nuclei. Thenumber of myeloblasts is increased.Peripheral blood may have ovalmacrocytic red cells, hypogranulargranulocytes with pseudo-Pelger-Huët anomaly, and giant platelets.
ASSOCIATED SYNDROMESThe 5q syndrome. This disorderis caused by a deletion of a longarm of chromosome 5. Approximately70% of patients are women.
The syndrome has a prolongedcourse with less than a 25% chance ofprogression to leukemia. The patient'splatelet count usually is high.Red blood cell transfusions and managementof iron overload are themainstays of treatment.
Hypoplastic myelodysplasia.It is difficult to distinguish this disorderfrom aplastic anemia. The bonemarrow has less than 25% cellularity.The natural history of myelodysplasiawith hypocellular marrow is similarto normocellular or hypercellularmyelodysplasia; however, it appearsto be a distinct clinicopathologic entitythat is characterized by marrowhypoplasia, macrocytosis, severeleukopenia and thrombocytopenia,and a low incidence of progression toacute leukemia. The disorder is unresponsiveto conventional therapy;pyridoxine, folic acid, prednisone, anabolicsteroids, retinoids, and lowdosecytosine arabinoside, which areminimally effective in normocellulardisease, are not beneficial in patientswith the hypoplastic disorder.14
Childhood myelodysplasia. Thesymptoms of the childhood diseaseare similar to those in adults. Aboutone third of affected children haveDown syndrome; more than 40% ofpatients develop AML.15
Usually, the disease is found inchildren younger than 2 years. Typically,their hemoglobin F level isgreater than 10%. The presence of refractoryanemia with excess blastsand refractory anemia with excessblasts in transformation is associatedwith a poor outcome.
Bone marrow fibrosis. Somepatients with myelodysplasia have increasedreticulin fibrosis in the marrow,a condition that can be confusedwith primary (agnogenic) myelofibrosis.However, myelodysplasia may bedistinguished by trilineage dysplasia,prominent splenomegaly, and the absenceof hepatomegaly.
TREATMENT
Myelodysplastic syndromes arehighly resistant to treatment. Supportivetherapies include transfusions,antibiotics, deferoxamine, anderythropoietin. A small number of patientsmay be helped by pyridoxine.
Treatments similar to those usedfor patients with AML have beentried. The remission rate after inductionof anthracycline and cytarabine is50% to 60%; relapses occur in about90% of those patients with myelodysplasticsyndromes. 16Patients with preexistingmyelodysplastic syndromehave a lower remission rate, shorterperiods of remission, and a higher incidenceof relapse.
Other treatments that have beentried include topotecan, hexamethylenebisacetamide, 5-aza-2'-deoxycytidine,and amifostine (organic thiophosphate).Antithymocyte globulinand antibody against CD33 are alsoused. Granulocyte colony-stimulatingfactor, granulocyte-macrophagecolony-stimulating factor, interleukins(IL-6 and IL-11), and interferon-αhave been beneficial in a few patients.Stem-cell transplantation is now theprimary curative therapy, especiallyfor younger patients.
References:
REFERENCES:1. Heaney ML, Golde DW. Medical progress:myelodysplasia. N Engl J Med. 1999;340:1649-1660.
2. Warrell RP Jr, Frankel SR, Miller WH Jr, et al.Differentiation therapy of acute promyelocyticleukemia with tretinoin (all-trans-retinoic acid).N Engl J Med. 1991;324:1385-1393.
3. Greenberg PL. The smoldering myeloid leukemicstates: clinical and biologic features. Blood. 1983;61:1035-1044.
4. Mallarmé PJ. Les débuts hématologiques desleucoses malignes. Sang. 1949;20:429-433.
5. Hamilton-Patterson JL. Preleukaemic anaemia.Acta Haematol. 1949;2:309-316.
6. Block M, Jacobson LO, Bethard WF. Preleukemicacute human leukemia. JAMA. 1953;152:1018-1028.
7. Cole P, Sateren W, Delzell E. Epidemiologicperspectives on myelodysplastic syndromes andleukemia. Leuk Res. 1995;19:361-365.
8. Golde DW. The stem cell. Sci Am. 1991;265:86-93.
9. Ogawa M. Differentiation and proliferation ofhematopoietic stem cells. Blood. 1993;81:2844-2853.
10. Koeffler HP, Golde DW. Human preleukemia.Ann Intern Med. 1980;93:347-353.
11. Huang ME, Ye YC, Chen SR, et al. Use of all-transretinoic acid in the treatment of acute promyelocyticleukemia. Blood. 1988;72:567-572.
12. Rajapaksa R, Ginzton N, Rott LS, GreenbergPL. Altered oncoprotein expression and apoptosisin myelodysplastic syndrome marrow cells. Blood.1996;88:4275-4287.
13. Mundle SD, Venugopal P, Cartlidge JD, et al.Indication of an involvement of interleukin-1 betaconverting enzyme-like protease in intramedullaryapoptotic cell death in the bone marrow of patientswith myelodysplastic syndromes. Blood. 1996;88:2640-2647.
14. Nand S, Godwin JE. Hypoplastic myelodysplasticsyndrome. Cancer. 1988;62:958-964.
15. Luna-Fineman S, Shannon KM. Myelodysplasticand myeloproliferative disorders of childhood: a studyof 167 patients. Blood. 1999;93:459-466.
16. Economopoulos T, Papageorgiou E. Treatmentof high-risk myelodysplastic syndromes with idarubicinand cytosine arabinoside supported by granulocyte-macrophage colony-stimulating factor(GM-CSF). Leuk Res. 1996;20:385-390.
17. Bennett JM, Catovsky D, Daniel MT, et al. Proposalsfor the classification of the myelodysplasticsyndromes. Br J Haematol. 1982;51:189-199.
18. Memorial Sloan-Kettering Cancer Center.Myelodysplastic syndrome. Available at:http://www.mskcc.org/mskcc/html. UpdatedFebruary 25, 2002. Accessed April 25, 2002.
